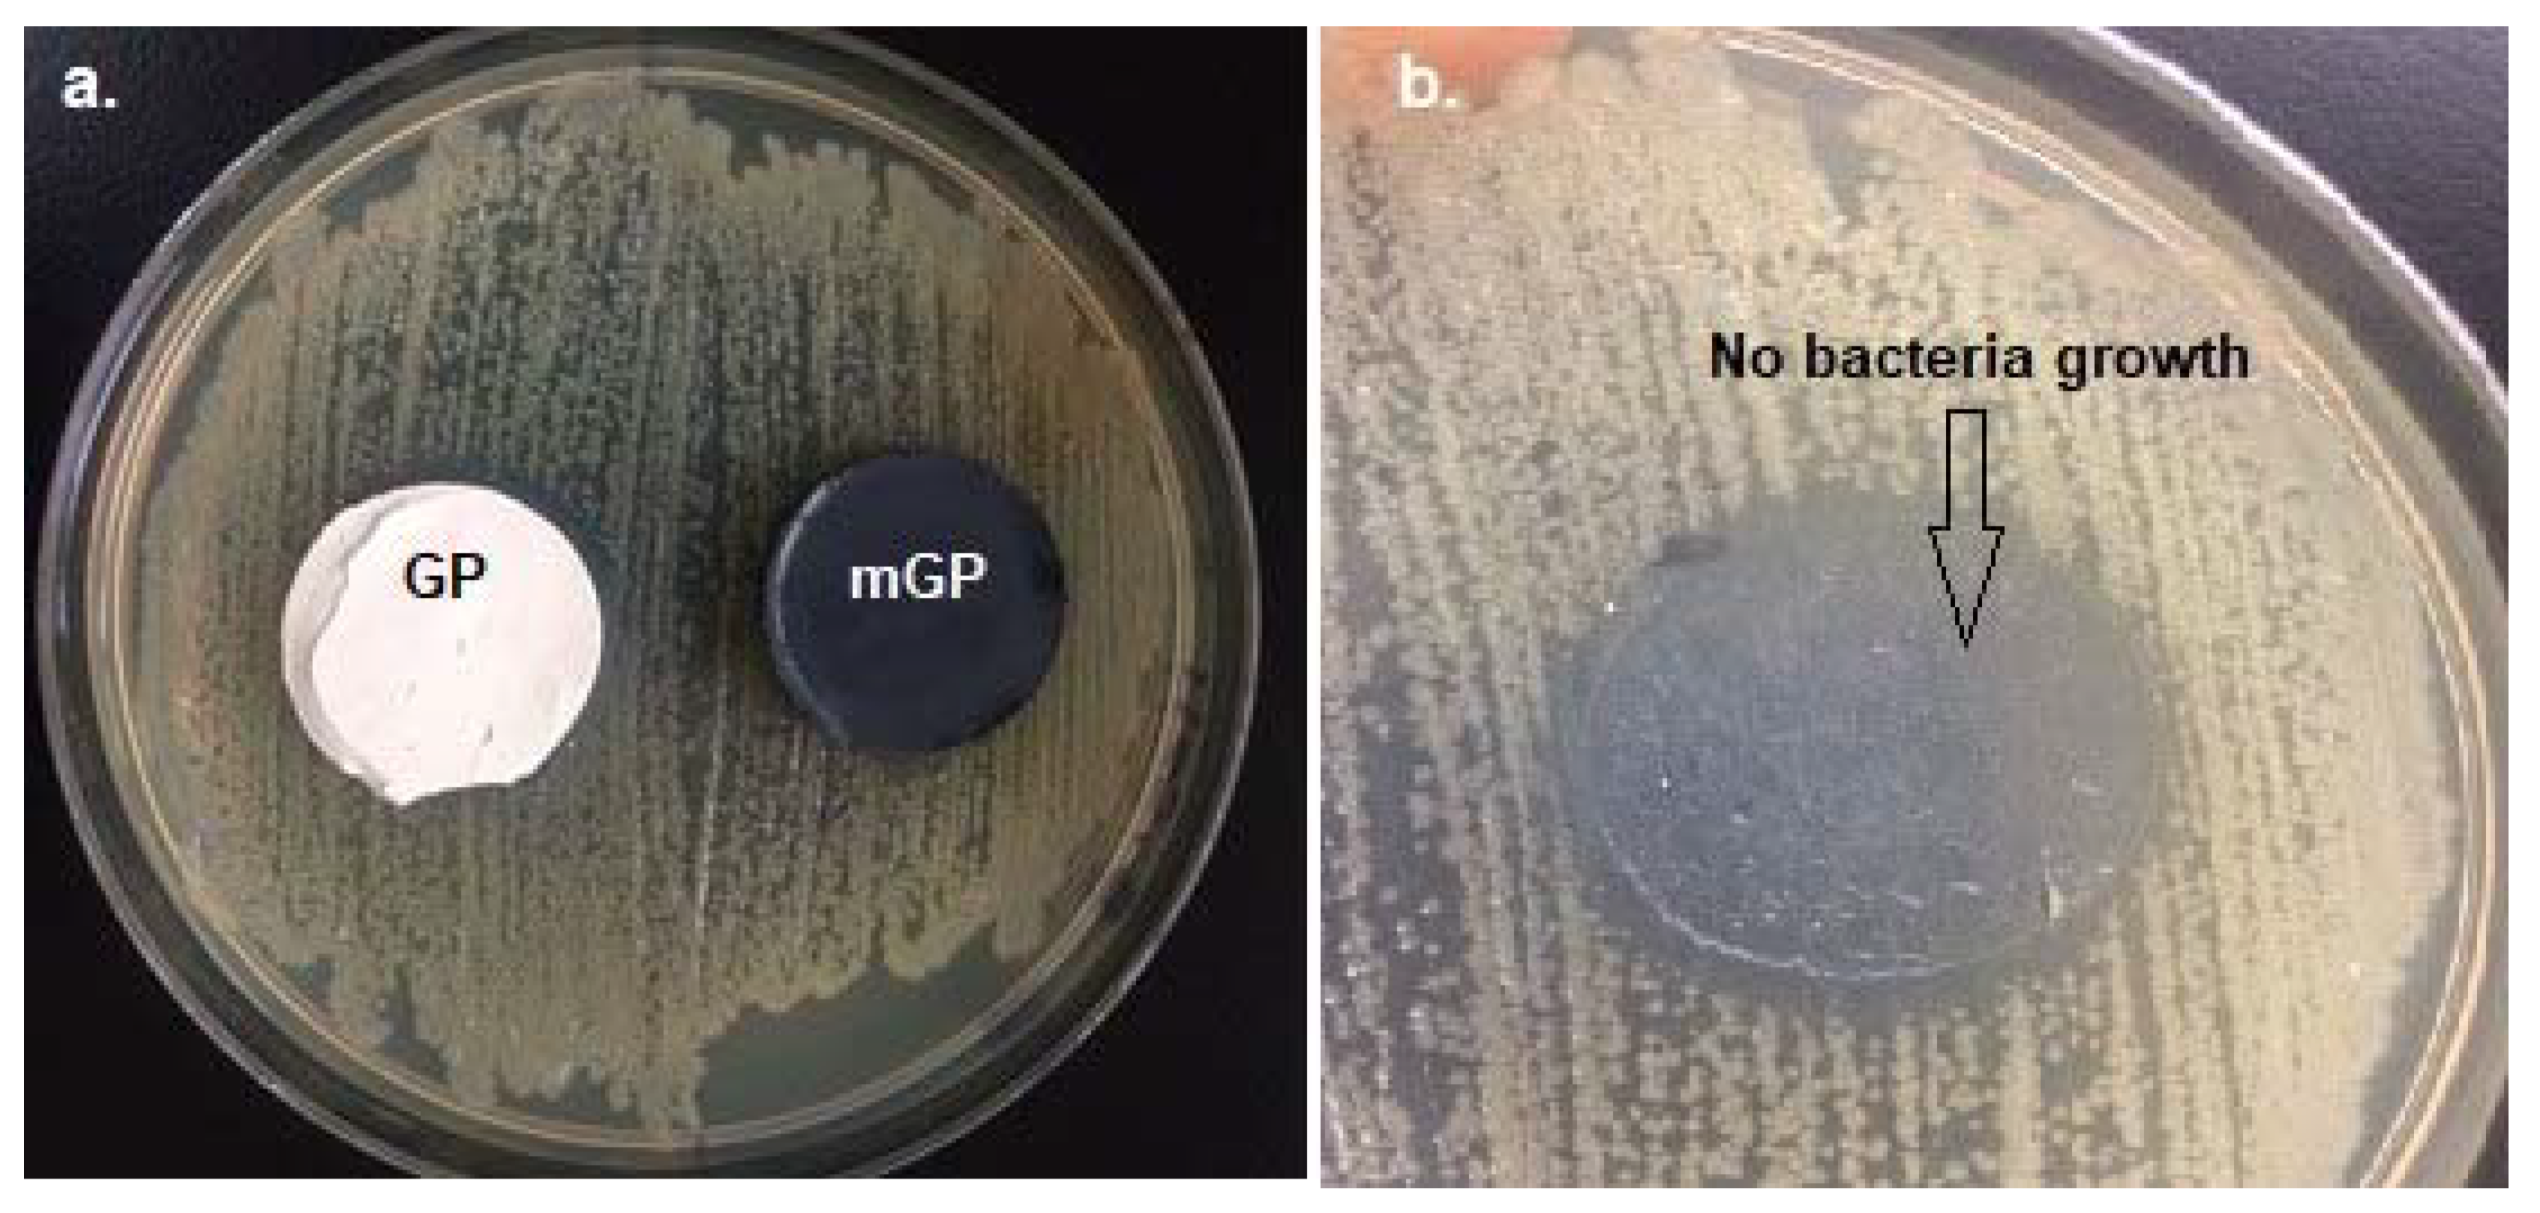
Coatings 10 00157 g008
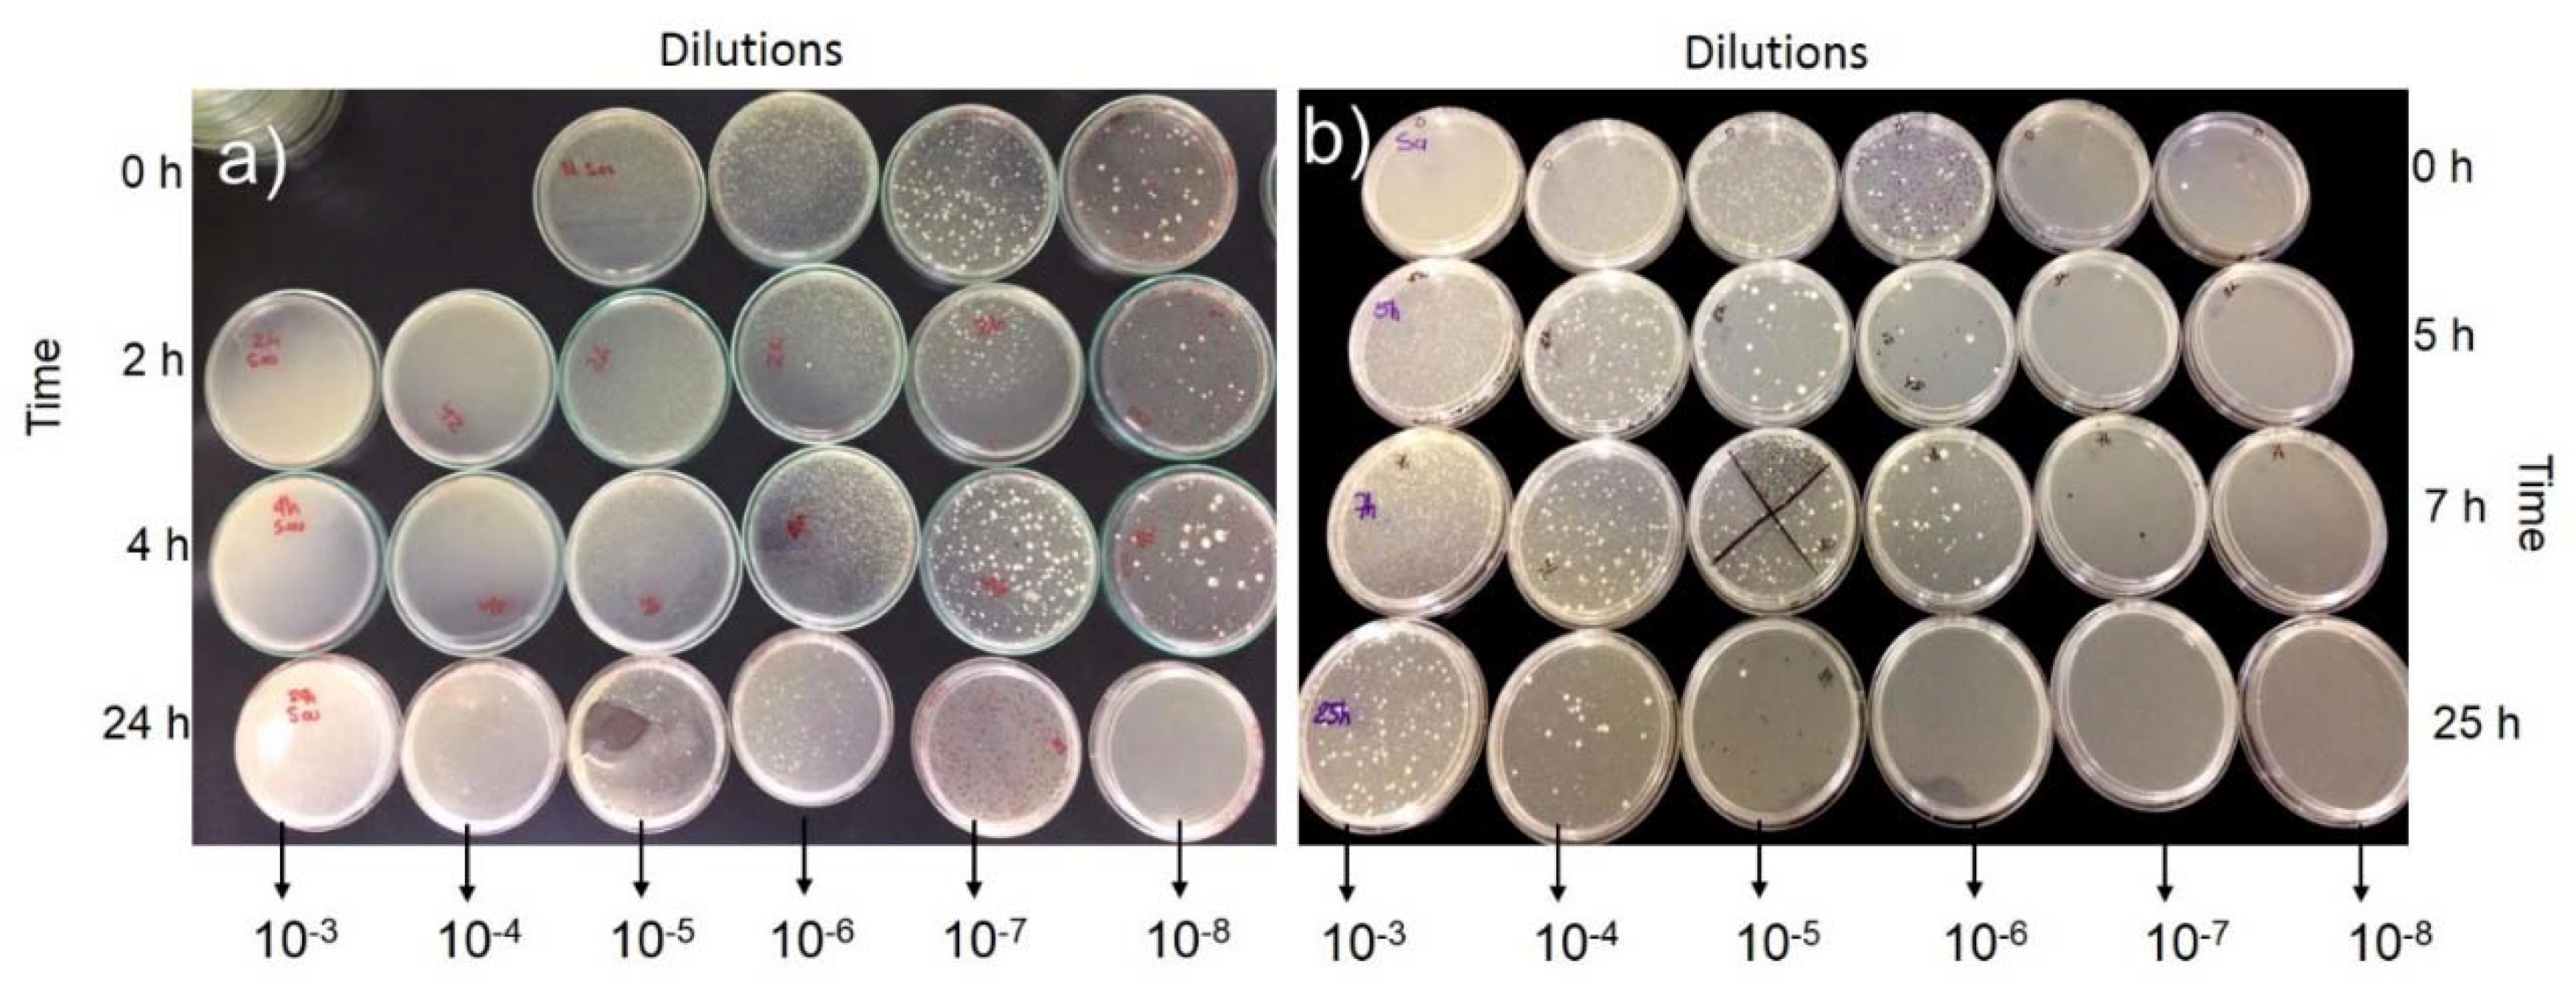
Coatings 10 00157 g009
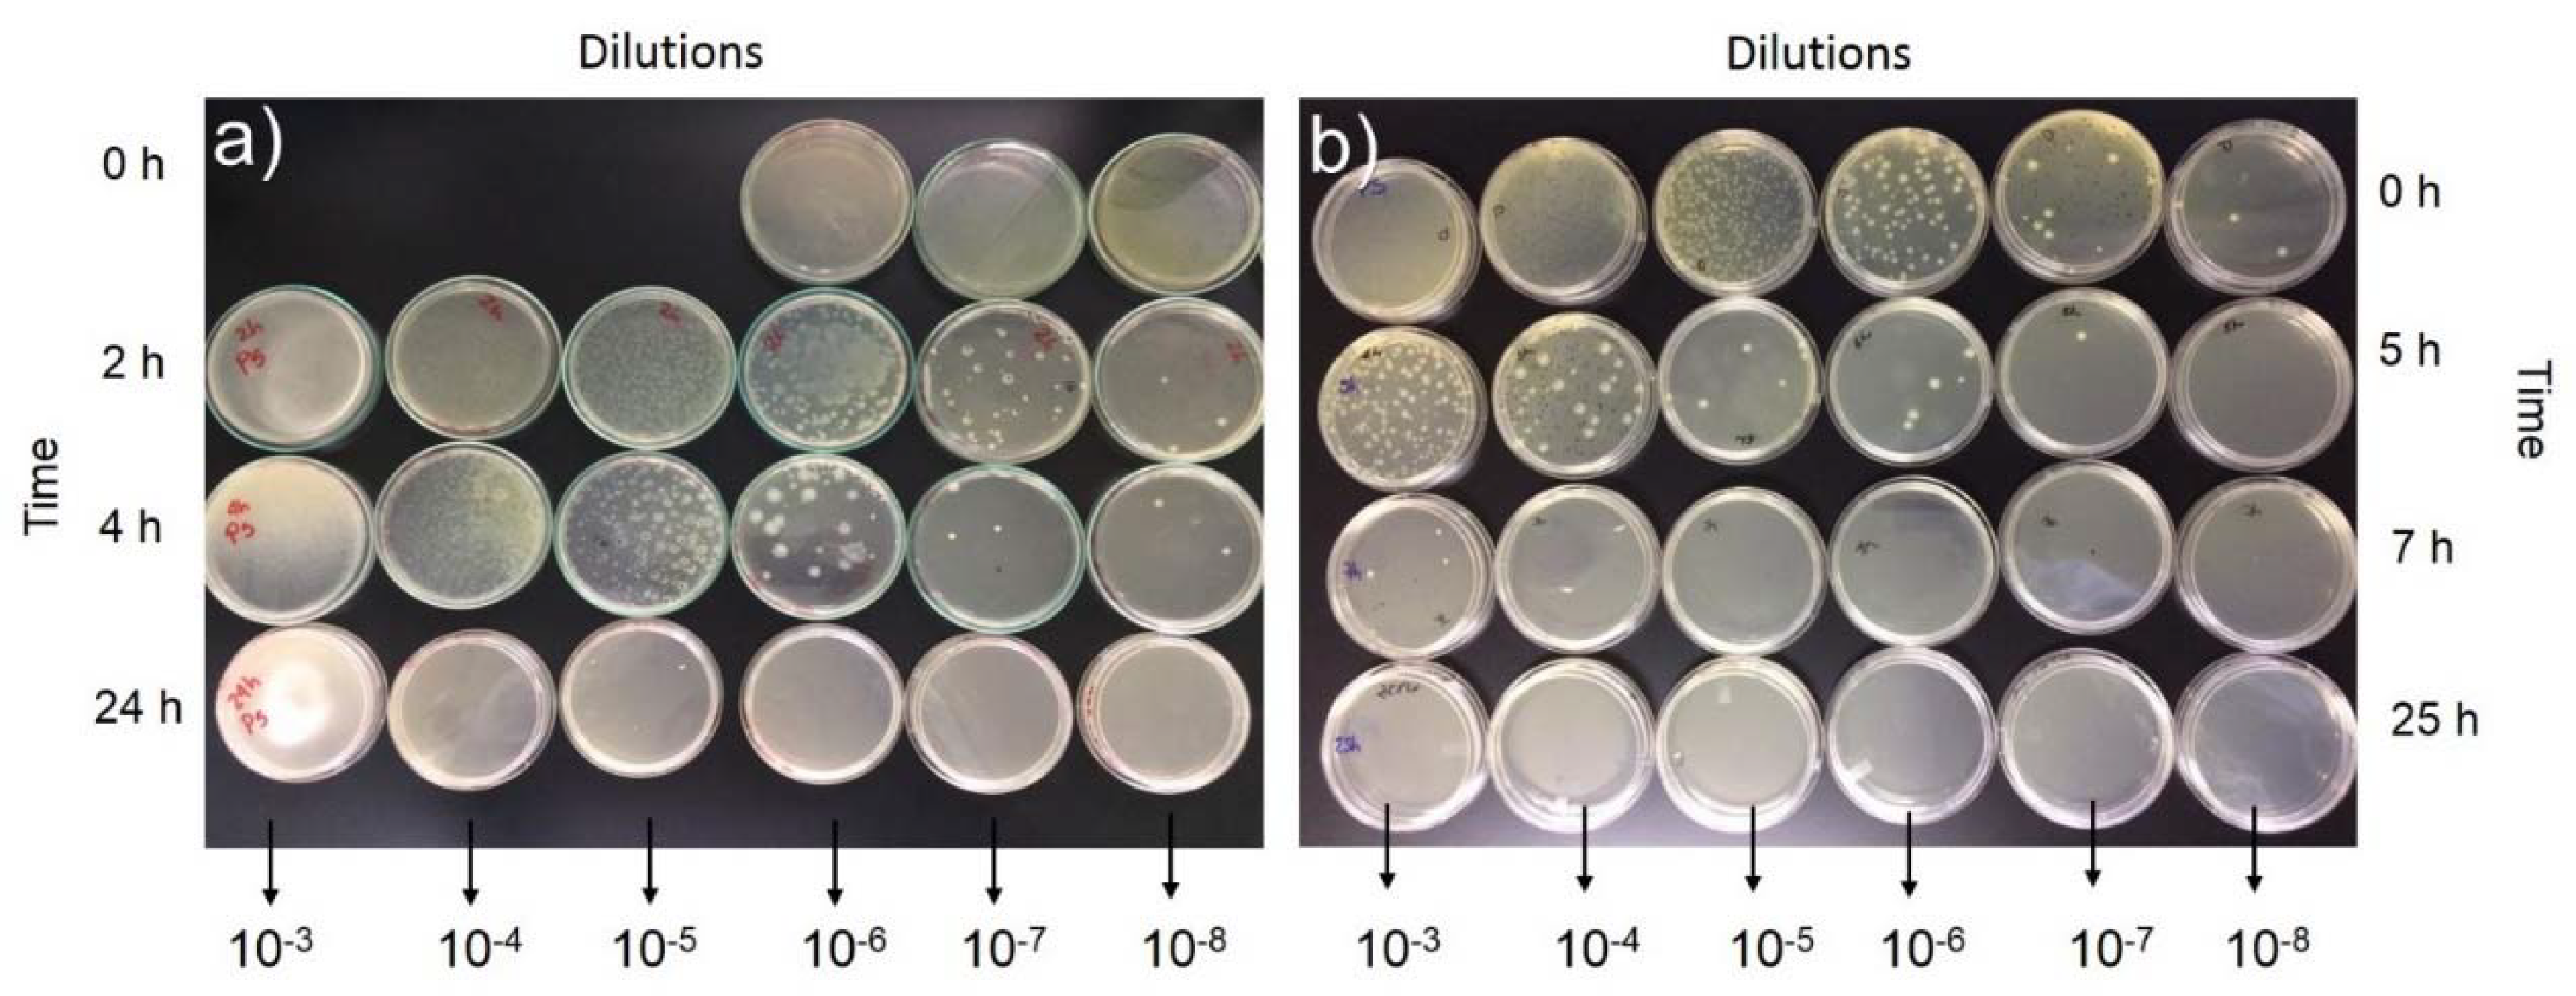
Coatings 10 00157 g010
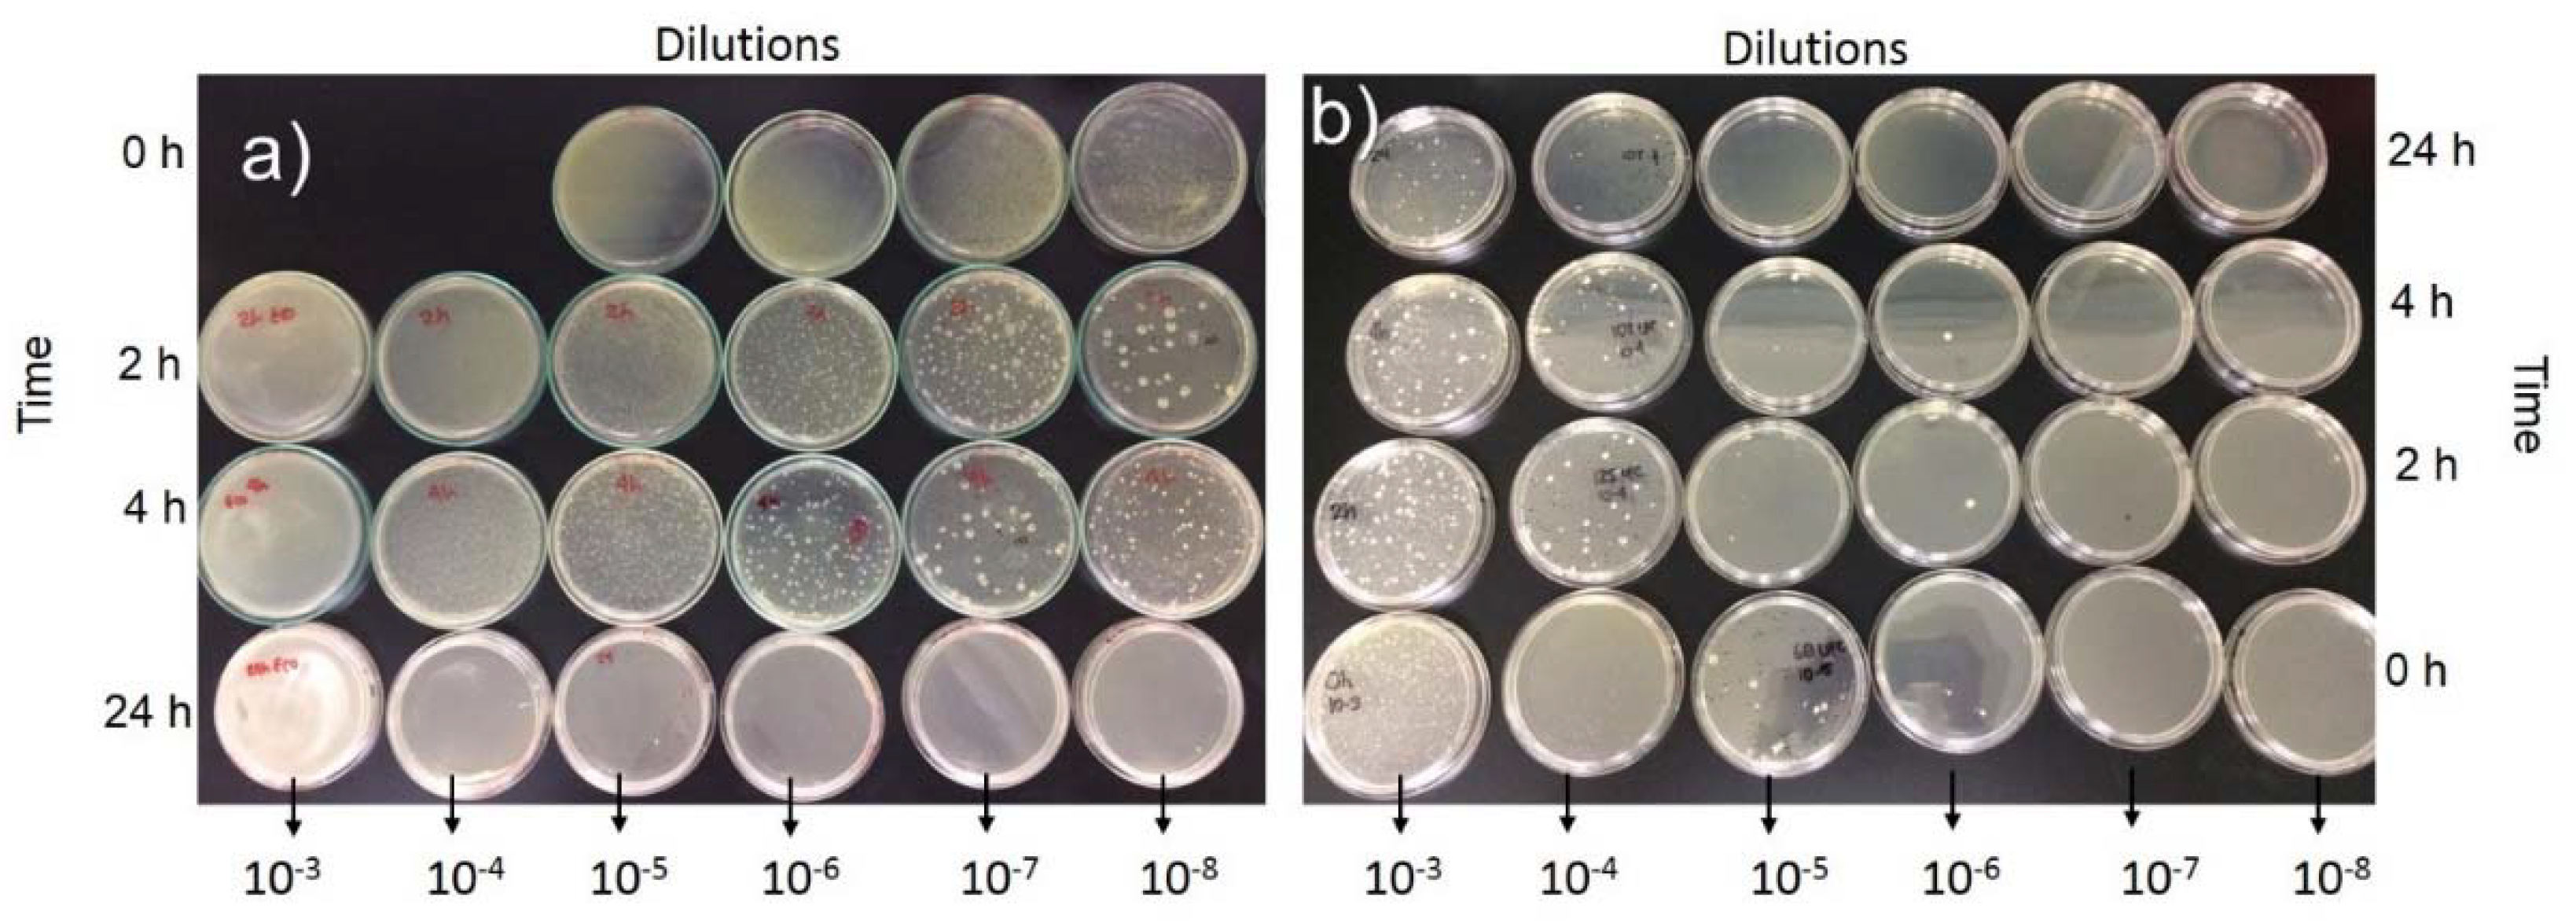
Coatings 10 00157 g011

Evaluation of the Antibacterial Activity of a Geopolymer Mortar Based on Metakaolin Supplemented with TiO2 and CuO Particles Using Glass Waste as Fine Aggregate
Abstract
1. Introduction
2. Materials and Methods
2.1. Materials
2.2. Preparation of the Geopolymers
2.3. Physicochemical and Microstructural Characterization Techniques
- The chemical composition of the starting materials was determined by X-ray fluorescence (XRF) using a Magix Pro PW-2440 X-ray fluorescence spectrometer (PANalytical, Tollerton, Nottingham, UK) equipped with a rhodium tube with a maximum output of 4.0 kW and 0.02% sensitivity.
- The X-ray diffraction (XRD) patterns were obtained with a RINT2000 wide-angle goniometer using Cu Kα radiation at 45 kV and 40 mA, and data were collected with a step size of 0.02° over the range of 5°–60° 2θ using a scan speed of 5°/min.
- Fourier-transform infrared spectroscopy (FTIR) was performed with a PerkinElmer Spectrum 100 spectrometer operated in transmittance mode, and data were collected for a wavelength range of 450 cm−1 to 4000 cm−1. The samples were prepared using the compressed KBr method.
- The morphological observations and particle sizes of TiO2 and CuO were evaluated by scanning electron microscopy (SEM) using a JEOL JSM-6490 LV SEM system operated with an accelerating voltage of 20 kV. The specimens were coated with gold, and the observations were made in vacuum mode.
- The density, pore volume, and water absorption of the geopolymers were determined following the procedures detailed in the ASTM C642-13 standard, except that the temperature used to dry the sample in the oven was 60 °C for 48 h.
2.4. Evaluation of the Antibacterial Activity of the Geopolymeric Materials
3. Results and Analysis
3.1. Physicochemical and Microstructural Characterization of the Starting Materials and the Produced Geopolymers
3.2. Assays with Bacteria
4. Conclusions
- Here, 10 wt.% TiO2 used for the manufacture of geopolymeric pastes and mortars showed satisfactory elimination of bacterial growth. In contrast, 5 wt.% CuO did not inhibit bacterial growth.
- The incorporation of glass wastes as fine aggregate endowed the GP-G with a 56.73% lower water absorption compared to the GP sample. Likewise, the glass particles endowed the material with a smoother and more homogeneous surface, 40.36% higher density, and 37.97% lower pore volume.
- The use of ground glass particles maximized the capacity for inhibiting CFU growth after 5 h for the GP-G mortars in solutions of 10−7 mL containing the three bacteria evaluated (S. aureus, P. aeruginosa, and E. coli).
- After 24 h in the bacterial culture, the GP-G mortars exhibited a high capacity for inhibiting the growth of P. aeruginosa in the 10−4 mL solutions and E. coli and S. aureus in the 10−6 mL solutions.
- These results indicate the potential for using the MK-based geopolymer composite with 10 wt.% TiO2 for applications on surfaces with antibacterial properties.
Author Contributions
Funding
Conflicts of Interest
References
- Ang, T.; He, Y.; Xiangxin, X.; Yong, L. Antibacterial Ceramic Fabricated by the Ti-Bearing Blast Furnace Slag. In Proceedings of the 8th Pacific Rim International Congress on Advanced Materials and Processing, Hilton Waikoloa Village in Waikoloa, HI, USA, 4–9 August 2013; Marquis, F., Ed.; Springer: Cham, Switzerland, 2016; pp. 1627–1634. [Google Scholar]
- Baheiraei, N.; Moztarzadeh, F.; Hedayati, M. Preparation and antibacterial activity of Ag/SiO2 thin film on glazed ceramic tiles by sol-gel method. Ceram. Int. 2012, 38, 2921–2925. [Google Scholar] [CrossRef]
- Wang, L.; Hu, C.; Shao, L. The antimicrobial activity of nanoparticles: Present situation and prospects for the future. Int. J. Nanomed. 2017, 12, 1227–1249. [Google Scholar] [CrossRef] [PubMed]
- Salgado, C.D.; Farr, B.M.; Calfee, D.P. Community-Acquired Methicillin-Resistant Staphylococcus aureus: A Meta-Analysis of Prevalence and Risk Factors. Clin. Infect. Dis. 2003, 36, 131–139. [Google Scholar] [CrossRef]
- Gelatti, L.C.; Bonamigo, R.R.; Matsiko-Inoue, F.M.; Do-Carmo, S.; Becker, A.P.; Da Silva-Castrucci, F.M.; Campos Pignatari, A.C.; Dazevedo, P.A. Community-acquired methicillin-resistant staphylococcus aureus carrying sccmec type IV in southern Brazil. Rev. Soc. Bras. Med. Trop. 2013, 46, 34–38. [Google Scholar] [CrossRef][Green Version]
- Drugă, B.; Ukrainczyk, N.; Weise, K.; Koenders, E.; Lackner, S. Interaction between wastewater microorganisms and geopolymer or cementitious materials: Biofilm characterization and deterioration characteristics of mortars. Int. Biodeterior. Biodegrad. 2018, 134, 58–67. [Google Scholar] [CrossRef]
- Crocker, J. Antibacterial Materials. Mater. Sci. Technol. 2007, 22, 238–241. [Google Scholar] [CrossRef]
- Abdel-Gawwad, H.A.; Mohamed, S.A.; Mohammed, M.S. Recycling of slag and lead-bearing sludge in the cleaner production of alkali activated cement with high performance and microbial resistivity. J. Clean. Prod. 2019, 220, 568–580. [Google Scholar] [CrossRef]
- Hasmaliza, M.; Foo, H.S.; Mohd, K. Anatase as Antibacterial Material in Ceramic Tiles. Procedia Chem. 2016, 19, 828–834. [Google Scholar] [CrossRef]
- Dahiya, M.S.; Tomer, V.K.; Duhan, S. Bioactive glass/glass ceramics for dental applications. In Applications of Nanocomposite Materials in Dentistry; Abdullah, M., Mohammad, I., Mohammad, A., Eds.; Woodhead Publishing Series in Biomaterials: Cambridge, UK, 2018; pp. 1–25. [Google Scholar]
- Guzmán-Aponte, L.; Mejía de Gutiérrez, R.; Maury-Ramírez, A. Metakaolin-Based Geopolymer with Added TiO2 particles: Physicomechanical Characteristics. Coatings 2017, 7, 233. [Google Scholar] [CrossRef]
- Mohd Adnan, M.A.; Muhd Julkapli, N.; Amir, M.N.I.; Maamor, A. Effect on different TiO2 photocatalyst supports on photodecolorization of synthetic dyes: A review. Int. J. Environ. Sci. Technol. 2019, 16, 547–566. [Google Scholar] [CrossRef]
- Rai, M.; Yadav, A.; Gade, A. Silver nanoparticles as a new generation of antimicrobial. Biotechnol. Adv. 2009, 27, 76–83. [Google Scholar] [CrossRef] [PubMed]
- Ming-Zhi, G.; Tung-Chai, L.; Chi-Sun, P. Nano-TiO2-based architectural mortar for NO removal and bacteria inactivation: Influence of coating and weathering conditions. Cem. Concr. Compos. 2013, 36, 101–108. [Google Scholar]
- Román, L.E.; Castro, F.; Maúrtua, D.; Condori, C.; Vivas, D.; Bianclii, A.E.; Paraguay-Delgado, F.; Solis, J.L.; Gómez, M.M. CuO nanoparticles and their antimicrobial activity against nosocomial strains. Rev. Colomb. Quim. 2017, 46, 28–36. [Google Scholar]
- Sikora, P.; Augustyniak, A.; Cendrowski, K.; Nawrotek, P.; Mijowska, E. Antimicrobial activity of Al2O3, CuO, Fe3O4, and ZnO nanoparticles in scope of their further application in cement-based building materials. Nanomaterials 2018, 8, 212. [Google Scholar] [CrossRef] [PubMed]
- Toodehzaeim, M.H.; Zandi, H.; Meshkani, H.; Hosseinzadeh Firouzabadi, A. The Effect of CuO Nanoparticles on Antimicrobial Effects and Shear Bond Strength of Orthodontic Adhesives. J. Dent. 2018, 19, 1–5. [Google Scholar]
- Yang, S.; Zhang, Y.; Yu, J.; Zhen, Z.; Huang, T.; Tang, Q.; Chu, P.K.; Qi, L.; Lv, H. Antibacterial and mechanical properties of honeycomb ceramic materials incorporated with silver and zinc. Mater. Des. 2014, 59, 461–465. [Google Scholar] [CrossRef]
- Haider, A.J.; Anbari, R.; Kadhim, G.R.; Salame, C.T. Exploring potential environmental applications of TiO2 nanoparticles. Energy Procedia 2017, 119, 332–345. [Google Scholar] [CrossRef]
- Kumar, A.M.; Khan, A.; Suleiman, R.; Qamar, M.; Saravanan, S.; Dafalla, H. Bifunctional CuO/TiO2 nanocomposite as nanofiller for improved corrosion resistance and antibacterial protection. Prog. Org. Coat. 2018, 114, 9–18. [Google Scholar] [CrossRef]
- Mersian, H.; Alizadeh, M.; Hadi, N. Synthesis of zirconium doped copper oxide (CuO) nanoparticles by the Pechini route and investigation of their structural and antibacterial properties. Ceram. Int. 2018, 44, 20399–20408. [Google Scholar] [CrossRef]
- Armayani, M.; Pratama, M.A. The Properties of Nano Silver (Ag)-Geopolymer as Antibacterial Composite for Functional Surface Materials. Matec. Web Conf. 2017, 97, 01010. [Google Scholar] [CrossRef]
- Elbourne, A.; Crawford, R.J.; Ivanova, E.P. Nano-structured antimicrobial surfaces: From nature to synthetic analogues. J. Colloid Interface Sci. 2017, 508, 603–616. [Google Scholar] [CrossRef] [PubMed]
- Dizaj, S.M.; Lotfipour, F.; Barzegar-Jalali, M.; Zarrintan, M.H.; Adibkia, K. Antimicrobial activity of the metals and metal oxide nanoparticles. Mater. Sci. Eng. C 2014, 44, 278–284. [Google Scholar] [CrossRef] [PubMed]
- Åsbrink, S.; Norrby, L.J. A refinement of the crystal structure of copper (II) oxide with a discussion of some exceptional. Acta. Crystallogr. Sect. B 1970, 26, 8–15. [Google Scholar] [CrossRef]
- Mejía, J.M.; Mendoza, J.D.; Yucuma, J.; Mejía de Gutiérrez, R.; Mejía, D.E.; Astudillo, M. Mechanical, in-vitro biological and antimicrobial characterization as an evaluation protocol of a ceramic material based on alkaline activated metakaolin. Appl. Clay Sci. 2019, 178, 105141. [Google Scholar] [CrossRef]
- Falah, M.; MacKenzie, K.J.D. Synthesis and properties of novel photoactive composites of P25 titanium dioxide and copper (I) oxide with inorganic polymers. Ceram. Int. 2015, 41, 13702–13708. [Google Scholar] [CrossRef]
- Syamsidar, D.; Nurfadilla, S. The Properties of Nano TiO2-Geopolymer Composite as a Material for Functional Surface Application. MATEC Web Conf. 2017, 97, 01013. [Google Scholar] [CrossRef]
- Rodrigues Magalhaes, A.P.; Laura, B.S.; Gonzaga Lopes, L.; Rodrigues de Araujo, E.; Estrela, C.; Torres, E.M.; Figueiroa Bakuzis, A.; Carvalho Cardoso, P.; Santos Carriao, M. Nanosilver Application in Dental Cements. ISRN Nanotechnol. 2012, 2012, 6. [Google Scholar] [CrossRef]
- Wu, Y.; Lu, B.; Bai, T.; Wang, H.; Du, F.; Zhang, Y.; Cai, L.; Jiang, C.; Wang, W. Review. Geopolymer, green alkali activated cementitious material: Synthesis, applications and challenges. Constr. Build. Mater. 2019, 224, 930–949. [Google Scholar] [CrossRef]
- Mondragón-Figueroa, M.; Guzmán-Carrillo, H.; Rico, M.A.; Reyez-Araiza, J.L.; Pineda-Piñón, J.; López-Naranjo, E.J.; Columba-Palomares, M.C.; López-Romero, J.M.; Gasca-Tirado, J.R.; Manzano-Ramírez, A. Development of a Construction Material for Indoor and Outdoor, Metakaolinite-Based Geopolymer, with Environmental Properties. J. Mater. Sci. Eng. A 2019, 9, 131–142. [Google Scholar]
- Nur, Q.A.; Sari, N.U.; Harianti, S. Development of Geopolymers Composite Based on Metakaolin-Nano ZnO for Antibacterial Application. IOP Conf. Ser. Mater. Sci. Eng. 2017, 180, 012289. [Google Scholar] [CrossRef]
- Dela Cerna, K.; Janairo, J.I.; Promentilla, M.A. Development of nanosilver-coated geopolymer beads (AgGP) from fly ash and baluko shells for antimicrobial applications. MATEC Web Conf. 2019, 268, 05003. [Google Scholar] [CrossRef][Green Version]
- Dibyendu, A.; Manas, S.; Moumita, M.; Abiral, T.; Saroj, M.; Brajadulal, C.H. Anti-microbial efficiency of nano silver–silica modified geopolymer mortar for eco-friendly green construction technology. RSC Adv. 2015, 5, 64037. [Google Scholar]
- Sikora, P.; Augustyniak, A.; Cendrowski, K.; Horszczaruk, E.; Rucinska, T.; Nawrotek, P.; Mijowska, E. Characterization of mechanical and bactericidal properties of cement mortars containing waste glass aggregate and nanomaterials. Materials (Basel) 2016, 9, 701. [Google Scholar] [CrossRef] [PubMed]
- Centers for Disease Control & Prevention. Four Pediatric Deaths from Community-Acquired Methicillin-Resistant Staphylococcus aureus—Minnesota and North Dakota 1997–1999. Morb. Mortal. Wkly. Rep. 1999, 48, 707–710. [Google Scholar]
- Van Elsas, J.D.; Semenov, A.V.; Costa, R.; Trevors, J.T. Survival of Escherichia coli in the environment: Fundamental and public health aspects. ISME J. 2011, 5, 173–183. [Google Scholar] [CrossRef]
- Villaquirán-Caicedo, M.A. Studying different silica sources for preparation of alternative waterglass used in preparation of binary geopolymer binders from metakaolin/boiler slag. Constr. Build. Mater. 2019, 227, 116621. [Google Scholar] [CrossRef]
- Villaquirán-Caicedo, M.A.; Mejía-de Gutiérrez, R. Mechanical and microstructural analysis of geopolymer composites based on metakaolin and recycled silica. J. Am. Ceram. Soc. 2019, 102, 3653–3662. [Google Scholar] [CrossRef]
- Sunde, T.O.L.; Grande, T.; Einarsrud, M.A. Modified Pechini Synthesis of Oxide Powders and Thin Films. In Handbook of Sol-Gel: Science and Technology; Klein, L., Aparicio, M., Jitianu, A., Eds.; Springer: Cham, Switzerland, 2016; pp. 1–30. [Google Scholar]
- Mejía de Gutiérrez, R.; Villaquirán-Caicedo, M.A.; Guzmán-Aponte, L. Alkali-activated metakaolin mortars using glass waste as fine aggregate: Mechanical and photocatalytic properties. Constr. Build. Mater. 2020, 235, 117510. [Google Scholar] [CrossRef]
- Akl, A.; Nida, M. Antibacterial Activity of synthesized Copper Oxide Nanoparticles using Malva sylvestris Leaf Extract. SMU Med. J. 2015, 2, 91–101. [Google Scholar]
- Bernal, S.A.; Rodríguez, E.D.; Mejía de Gutierrez, R.; Provis, J.L.; Delvasto, S. Activation of Metakaolin/Slag Blends Using Alkaline Solutions Based on Chemically Modified Silica Fume and Rice Husk Ash. Waste Biomass Valoriz. 2011, 3, 99–108. [Google Scholar] [CrossRef]
- Villaquiran-Caicedo, M.A.; Mejía de Gutiérrez, R. Synthesis of ternary geopolymers based on metakaolin, boiler slag and rice husk ash. Dyna 2015, 82, 104–110. [Google Scholar] [CrossRef]
- Arellano-Aguilar, R.; Burciaga-Díaz, O.; Gorokhovsky, A.; Escalante-García, J.I. Geopolymer mortars based on a low grade metakaolin: Effects of the chemical composition, temperature and aggregate:binder ratio. Constr. Build. Mater. 2014, 50, 642–648. [Google Scholar] [CrossRef]
- Tchakouté, H.K.; Rüscher, C.H.; Kong, S.; Kamseu, E.; Leonelli, C. Geopolymer binders from metakaolin using sodium waterglass from waste glass and rice husk ash as alternative activators: A comparative study. Constr. Build. Mater. 2016, 114, 276–289. [Google Scholar] [CrossRef]
- Lin, K.L.; Shiu, H.S.; Shie, J.L.; Cheng, T.W.; Hwang, C.L. Effect of composition on characteristics of thin film transistor liquid crystal display (TFT-LCD) waste glass-metakaolin-based geopolymers. Constr. Build. Mater. 2012, 36, 501–507. [Google Scholar] [CrossRef]
- Elimbi, A.; Tchakouté, H.K.; Njopwouo, D. Effects of calcination temperature of kaolinite clays on the properties of geopolymer cements. Build. Mater. 2011, 25, 2805–2812. [Google Scholar] [CrossRef]
- Covarrubias, C.; García, R.; Arriagada, R.; Yánez, J.; Garland, M.T. Cr (III) exchange on zeolites obtained from kaolin and natural mordenite. Microporous Mesoporous Mater. 2006, 88, 220–231. [Google Scholar] [CrossRef]
- Sunada, K.; Watanabe, T.; Hashimoto, K. Studies on photokilling of bacteria on TiO2 thin film. J. Photochem. Photobiol. A: Chem. 2003, 156, 227–233. [Google Scholar] [CrossRef]
- Dakal, T.C.; Kumar, A.; Majumdar, R.S.; Yadav, V. Mechanistic basis of antimicrobial actions of silver nanoparticles. Front. Microbiol. 2016, 7, 1–17. [Google Scholar] [CrossRef]
- Marugan, J.; Grieken, R.V.; Pablos, C.; Sordo, C. Analogies and differences between photocatalytic oxidation of chemicals and photocatalytic inactivation of microorganisms. Water Res. 2010, 44, 789–796. [Google Scholar] [CrossRef]

| ID | Geopolymer (GP) Type | GP (wt.%) | TiO2 (wt.%) | CuO (wt.%) |
|---|---|---|---|---|
| GP | Paste | 90 | 10 | 0 |
| mGP | Paste | 95 | 0 | 5 |
| GP-G | Mortar with glass waste (G) as fine aggregate | 90 | 10 | 0 |
| Oxide/Material | SiO2 | Al2O3 | TiO2 | Fe2O3 | Na2O | MgO | K2O | P2O5 | CaO | CeO2 | V2O5 | SO3 |
|---|---|---|---|---|---|---|---|---|---|---|---|---|
| MK | 52.02 | 44.95 | 1.73 | 0.47 | 0.30 | 0.19 | 0.16 | 0.02 | 0.02 | 0.04 | 0.05 | 0.05 |
| G | 72.27 | 1.49 | – | 0.62 | 13.37 | – | – | – | 11.15 | – | – | – |
| Sample | Paste without TiO2 [11] | GP (Paste) (10 wt.% TiO2) | GP-G (Mortar) (10 wt.%TiO2 + G) |
|---|---|---|---|
| Absorption after immersion (%) | 27.25 ± 0.15 | 26.18 ± 0.42 | 11.54 ± 0.26 |
| Dry density (kg/m3) | 1291 ± 0.25 | 1365 ± 0.02 | 1916 ± 140 |
| Volume of permeable pores (%) | 36.18 ± 0.34 | 36.73 ± 0.90 | 22.78 ± 1.97 |
| Sample | Bacteria/Formation of Halo/Halo Size | ||
|---|---|---|---|
| Staphylococcus aureus | Escherichia coli | Pseudomonas aeruginosa | |
| GP | No—0 | Yes—0.5 mm | No—0 |
| mGP | No—0 | No—0 | No—0 |
| Sample, Time in Agar | Dissolutions (mL) | CFU * | ||
|---|---|---|---|---|
| S. aureus | P. aeruginosa | E. coli | ||
| GP, 4 h | 10−3 | ++ | ++ | ++ |
| 10−4 | ++ | ++ | ++ | |
| 10−5 | ++ | + | + | |
| 10−6 | + | + | + | |
| 10−7 | + | − | + | |
| 10−8 | + | − | + | |
| GP-G, 5 h | 10−3 | + | + | + |
| 10−4 | + | + | + | |
| 10−5 | + | + | + | |
| 10−6 | + | + | − | |
| 10−7 | − | − | − | |
| 10−8 | − | − | − | |
| Sample, Time in Agar | Dissolutions (mL) | Bacteria | ||
|---|---|---|---|---|
| S. aureus | P. aeruginosa | E. coli | ||
| GP, 24 h | 10−3 | ++ | ++ | ++ |
| 10−4 | ++ | ++ | + | |
| 10−5 | ++ | + | + | |
| 10−6 | + | − | − | |
| 10−7 | + | − | − | |
| 10−8 | − | − | − | |
| GP-G, 25 h | 10−3 | + | + | + |
| 10−4 | + | − | + | |
| 10−5 | + | − | + | |
| 10−6 | − | − | − | |
| 10−7 | − | − | − | |
| 10−8 | − | − | − | |
© 2020 by the authors. Licensee MDPI, Basel, Switzerland. This article is an open access article distributed under the terms and conditions of the Creative Commons Attribution (CC BY) license (http://creativecommons.org/licenses/by/4.0/).
Share and Cite
Gutiérrez, R.M.-d.; Villaquirán-Caicedo, M.; Ramírez-Benavides, S.; Astudillo, M.; Mejía, D. Evaluation of the Antibacterial Activity of a Geopolymer Mortar Based on Metakaolin Supplemented with TiO2 and CuO Particles Using Glass Waste as Fine Aggregate. Coatings 2020, 10, 157. https://doi.org/10.3390/coatings10020157
Gutiérrez RM-d, Villaquirán-Caicedo M, Ramírez-Benavides S, Astudillo M, Mejía D. Evaluation of the Antibacterial Activity of a Geopolymer Mortar Based on Metakaolin Supplemented with TiO2 and CuO Particles Using Glass Waste as Fine Aggregate. Coatings. 2020; 10(2):157. https://doi.org/10.3390/coatings10020157
Chicago/Turabian StyleGutiérrez, Ruby Mejía-de, Mónica Villaquirán-Caicedo, Sandra Ramírez-Benavides, Myriam Astudillo, and Daniel Mejía. 2020. "Evaluation of the Antibacterial Activity of a Geopolymer Mortar Based on Metakaolin Supplemented with TiO2 and CuO Particles Using Glass Waste as Fine Aggregate" Coatings 10, no. 2: 157. https://doi.org/10.3390/coatings10020157
APA StyleGutiérrez, R. M.-d., Villaquirán-Caicedo, M., Ramírez-Benavides, S., Astudillo, M., & Mejía, D. (2020). Evaluation of the Antibacterial Activity of a Geopolymer Mortar Based on Metakaolin Supplemented with TiO2 and CuO Particles Using Glass Waste as Fine Aggregate. Coatings, 10(2), 157. https://doi.org/10.3390/coatings10020157






